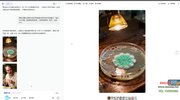
视频号分成计划快速变现，持续爆火的科普赛道玩法全解析

视频号分成计划快速变现,持续爆火的科普赛道玩法全解析
作者:坚韧*拔的老虎
资源分类:网盘资源
入库时间:2025-11-13 07:23:56
分享时间:2025-09-12 07:59:49
资源分类:网盘资源
入库时间:2025-11-13 07:23:56
分享时间:2025-09-12 07:59:49
内容摘要:视频号分成计划快速变现,持续爆火的科普赛道玩法全解析_项目实操+项目变现 (1)_项目介绍+项目搭建 (1)_指令_【风险提示新人必看】课程及时保存,课程容易失效
标签:
相关推荐: